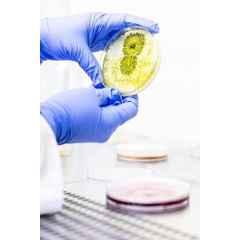

Electrical & Appliances
Industrial Tools
Office Supplies
Agri & Gardening
Medical & Lab Supplies
Safety Supplies
Construction Materials
Automotive
Packaging & Material Handling

Hover to Zoom
Labsoul 47mm 0.45µm Cellulose Nitrate Membrane Filter Paper
₹1,146 (Incl. of all taxes)
₹971 ₹175 GST
MRP ₹1,499 23% OFF
About This Product
Product Specifications
Brand | |
Application | Biological Filters, Chemistry Lab & Industrial Experiments, Laboratory Activities for Schools |
Diameter | 47 mm |
Material | Cellulose |
Notes | Images are for Reference Purposes Only |
Pore Size | 0.45 µm |
Country of origin | India |
Manufacturer Details | R S Scientific, B-9/218 Sector-3 |
Packer Details | R S Scientific, B-9/218 Sector-3 |
Common/Generic Name | Filter Paper |
Dimensions LxWxH | 14x6x12 cm |
Weight | 0.5 kg |
Show All Specifications
Product Details
The Labsoul 47mm 0.45µm Cellulose Nitrate Membrane Filter Paper is an essential lab tool categorized under \
Browse through the extensive list of Other Lab Supplies at Moglix. Shop online for other Labsoul Other Lab Supplies. available at Moglix in the lowest price range.
Read More
Frequently Asked Questions Have doubts regarding this product?
₹1,146 (Incl. of all taxes)
₹971 ₹175 GST
MRP ₹1,499 23% OFF



